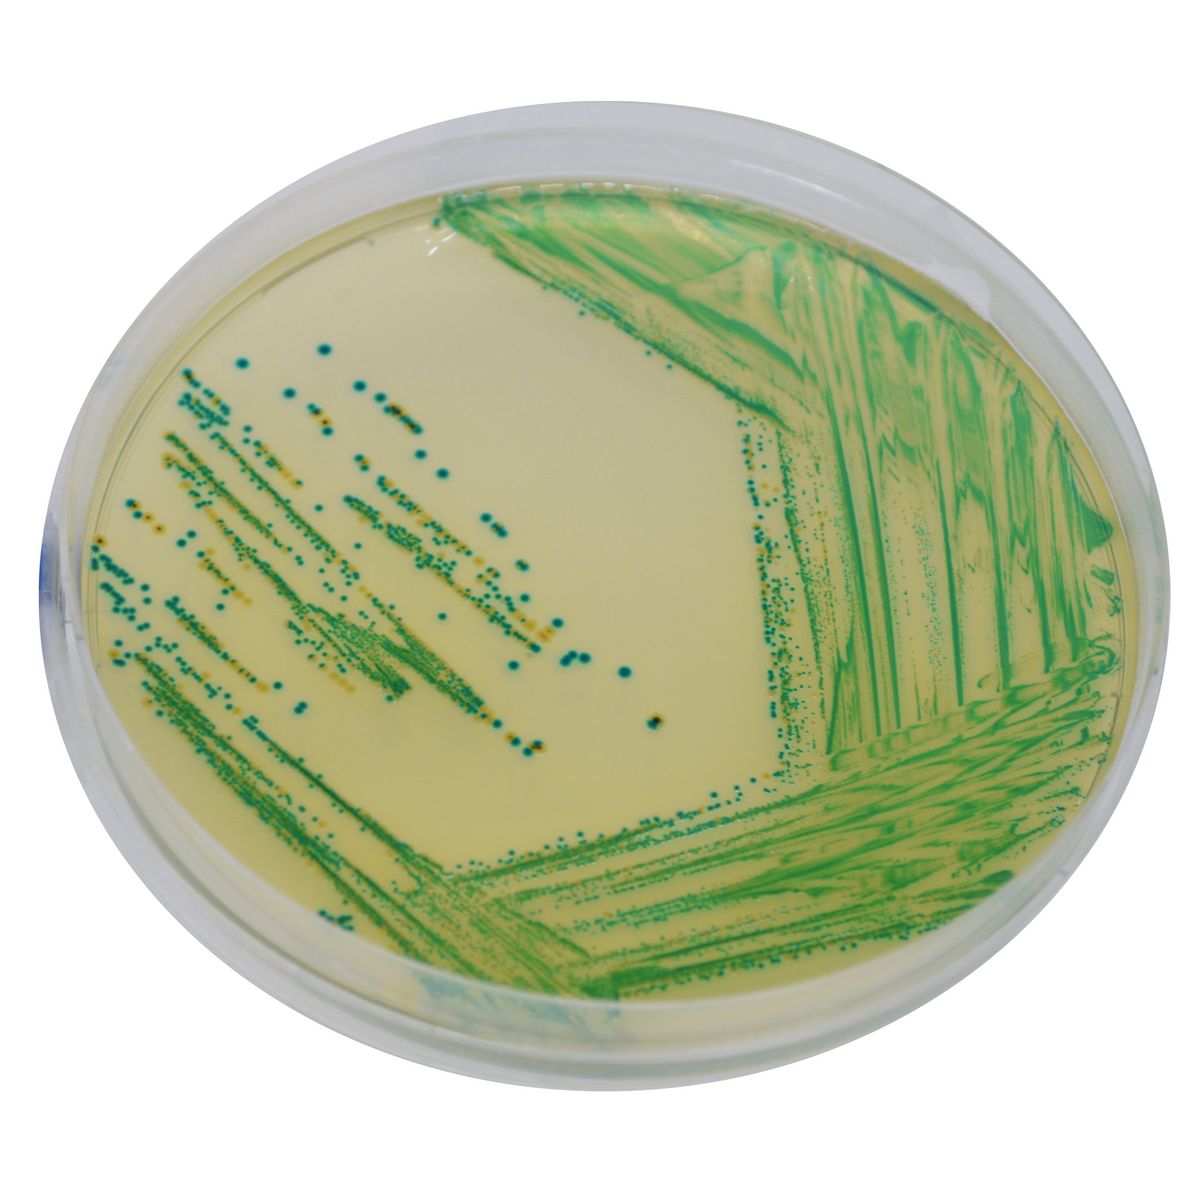
CHROMagar™ Cronobacter - 500 g

SQ001
For Rapid detection of Salmonella species including S. typhi, S. paratyphi and Salmonella lactose positive strains
Package size: 1000 ml
DKK 750,00
DKK 6.885,00
Not in stock, delivery 1-2 weeks
Chromogenic detection of Cronobacter spp. in food, in animal feed and in environmental samples.
The product is composed of a single powder medium.
MEDIUM PERFORMANCE:
1. ISO 22964 Standard: CHROMagar™Cronobacter is a chromogenic medium for detection of Cronobacter spp. in food, animal feed and environmental samples in accordance with the ISO 22964 standard.
2. Fast and easy: After incubation at 41.5 °C for 24 h, Cronobacter spp. will grow in Intense green to blue colonies while most other bacteria will be inhibited or grow in colourless colonies.
TYPICAL APPEARANCE OFMICROORGANISMS:
Cronobacter spp. → green to blue
Other Gram (-) → colorless, clear green, black, yellow
Gram (+) bacteria → inhibited
Cronobacter is an ubiquitous environmental microorganism found in water, soil, plants, dust and many other living things. Cronobacter has been isolated from many foods of plant or animal origin, both dehydrated, smoked, frozen, fermented, raw and cooked.